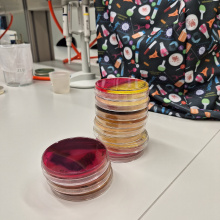
fot. dr Dorota Pomorska

Experiments, lectures and popular science games. On September 29, scientists revealed their secrets to all those interested. The Pomeranian Researchers' Night involved researchers from all over the voivodeship, including employees of the University of Gdańsk from the Faculties of Biology, Mathematics, Physics and Informatics, History, Chemistry, and the Intercollegiate Faculty of Biotechnology UG and MUG. At the UG, PRN’s participants were able to learn intriguing things about ghosts, jinns, and other creatures of the Islamic world culture or about the wonders of physics. View a photo report of the event.
Text and photo Marcel Jakubowski/ Press Office UG